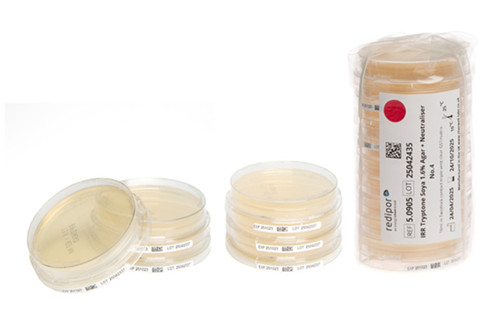

|
Specialist Products for Boosting Microbial EM Protocol Reliability Spotlighted by AnalytiChem UK at Pharmig 2025
hits:38 Date:11/12/25
AnalytiChem UK (formerly Cherwell) to demonstrate products aimed at ensuring reliability and reducing risk in microbial EM
AnalytiChem’s new locking lid Twistlock plates ensure EM sample security throughout the microbial monitoring process.
Bicester, UK, 11 November 2025: AnalytiChem UK (formerly Cherwell), microbiology solutions expert, is to exhibit at Pharmig’s 33rd Annual Conference focusing on ‘Hot Topics in Pharmaceutical Microbiology’. To be held at Nottingham Belfry Hotel, 19-20th November, AnalytiChem UK will highlight its range of products for environmental monitoring (EM) and process validation in sterile medicinal product manufacturing.
Among the hot topics to be discussed at the conference, aimed at advancing microbiological best practice in pharmaceutical and related industries, will be a focus on contamination control strategies (CCS) and rapid microbiological methods (RMM). Both will also be spotlighted by AnalytiChem at the event, where it will demonstrate its new Redipor® TwistLock locking prepared media plates, BAMS real-time microbial monitor and Redipor® BetaBag – all are designed to ensure reliability and reduce risk in microbiological EM protocols, which are a key component of an effective CCS.
Recently launched, AnalytiChem’s new range of locking lid Redipor Twistlock plates ensure EM sample security throughout the microbial monitoring process to deliver reliable data and uphold product safety. Switching to locking plates instead of standard loose-lidded culture media plates offers a simple yet impactful way to maintain sample integrity, from point of collection to final reading, and support a robust CCS.
AnalytiChem will also feature its Redipor BetaBag, another easy and effective way to reduce risk in EM. The BetaBag contains gamma-irradiated, ready-to-use microbiology media plates and supports EU GMP Annex 1 compliance by enabling validated, sterile transfer into Grade A environments. When connected to an Alpha port on an isolator or RABS, it provides a fully sealed, ‘no-touch’ transfer system, minimising operator contact and contamination risk. Gamma irradiation ensures sterility without additional decontamination steps, while the closed Alpha-Beta connection maintains containment integrity. These combined features provide validated, aseptic, and compliant material transfer, enhancing operator safety and contamination control.
The AnalytiChem UK team will be on hand to offer expert insight into developing reliable microbial EM programmes to support robust CCS. This expertise has been built from over 50 years’ experience and customer partnerships in the pharmaceutical and related industries. Microbiology Product Specialist, Yoggya De Silva and business development managers, Thomas Parkhill, Eleanor Corbett and Tom Pickford, will also be joined by colleagues from the global AnalytiChem Group.
“Reducing risk is fundamental to sterile pharmaceutical product manufacturing, and often small changes can deliver a big impact in achieving this. Through our high quality products, plus a flexible and reliable service with expert support, we help our customers to proactively manage risk,” said Yoggya De Silva, AnalytiChem UK. “Our long-standing heritage is built on forging strong partnerships and truly understanding our customers' needs, so we can provide the best guidance and support possible. Events like Pharmig give us a perfect opportunity to connect directly, deepen our industry insight, and stay current with the evolving needs of the pharmaceutical industry and our customers alike.”
Other specialist cleanroom microbiology products to be showcased on AnalytiChem UK’s stand at Pharmig’s annual conference include further products in its Redipor® prepared media range. Products contributing to sustainability initiatives, such as plastic bottled media and variably sized plated media packs, will be available. SAS microbial air samplers for active EM will also be on show alongside the BAMS real-time microbial monitors for continuous air monitoring.
For more information about AnalytiChem UK (formerly Cherwell), please visit www.cherwell-labs.co.uk, or follow us on LinkedIn.
About AnalytiChem UK (formerly Cherwell): www.cherwell-labs.co.uk
AnalytiChem UK is the new name for Cherwell Laboratories, a business founded in 1971 that became part of the AnalytiChem group in early 2024. It is the UK operation for the wider AnalytiChem Holding GmbH group; with locations across the globe in Europe, North America and Australia.
AnalytiChem UK manufactures and supplies cleanroom microbiology solutions to pharmaceutical and related industries across the UK and Europe from its site in Bicester, Oxfordshire. Helping its customers effectively manage their controlled environments and processes, the company has built a strong reputation as a leading supplier of prepared microbiological media and environmental monitoring equipment.
Through its ongoing integration within the AnalytiChem Group, AnalytiChemUK will be expanding its product and application offerings, building on its existing presence in the Food & Beverage Testing, Water Testing and Clinical Diagnostics markets, as well as continuing to serve the Pharmaceutical and related industries.
Manufacturing its extensive range of Redipor® prepared media products in its ISO9001 registered facility, AnalytiChem UK has the flexibility to respond to varying customer requirements - from routine high volume down to low volume specialist applications. In-house engineering facilities support production and the development of bespoke solutions, as well as the supply, service and calibration of its environmental air monitoring equipment solutions.
The company builds strong partnerships through professional, responsive and open communication. By delivering high quality products, plus a flexible and reliable service with expert support, AnalytiChem UK ultimately helps its customers to reduce risk.
|